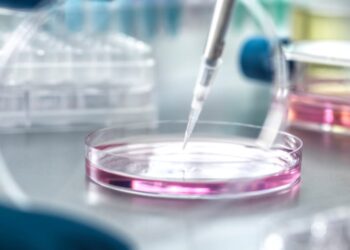
Collagen, NMN, longevity in research round-up

Ferrous Gluconate vs Ferrous Sulfate: 5 Key Differences to Know
January 17, 2025
10 Benefits of Bringing Sports Into Your Family Life
May 17, 2024
11 Reasons to Work with a Health Coach
May 10, 2024
European Commission clears three botanical ingredients
August 9, 2025
DIY Herbal Throat Spray Recipe
December 18, 2025
Biomarkers redefine skin health at London summit
December 18, 2025
Importance Of Vitamin D in Health to Improve Bone Structure
December 18, 2025
Fucoidan, multivitamins, Tongkat Ali in nutra research round-up
December 18, 2025